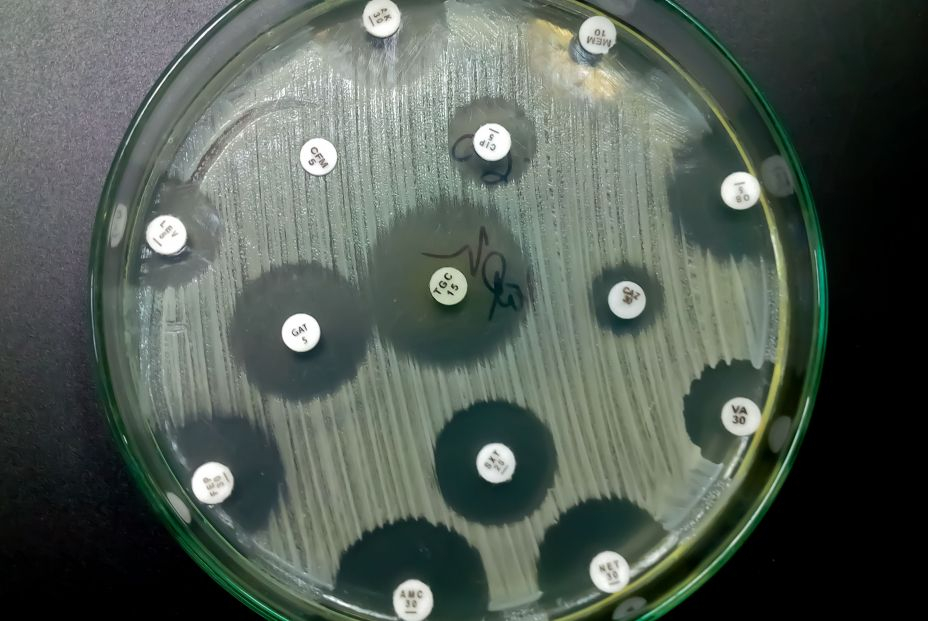
Descubren un compuesto químico capaz de eliminar las superbacterias

Antibióticos: descubren un compuesto químico capaz de eliminar las súper bacterias
Químicos de la Universidad de Illinois anuncian el fármaco Fabimycin, eficaz en ratones
Las súper bacterias o bacterias multirresistentes son aquellas que, debido a un mal uso de los antibióticos, han logrado restarles efectividad, lo que supone la expansión e incluso la reaparición de enfermedades que se creían superadas, como la tuberculosis. La OMS ya ha advertido de que este fenómeno se convertirá en uno de los mayores problemas de salud pública del siglo XXI.
Por ello, las farmacéuticas están trabajando en la creación de nuevos antibióticos que logren combatir este fenómeno emergente. El primer fármaco exitoso podría estar cerca: investigadores de la Universidad de Illinois (Estados Unidos) han anunciado un fármaco llamado Fabimycin que ya ha demostrado ser eficaz en ratones.
Súper bacterias, el nuevo villano
Hasta la aparición de los antibióticos en el siglo XX, las infecciones eran una de las causas de muerte más comunes a nivel mundial. Sin embargo, a partir de mediados de siglo, la proliferación de antibióticos redujo los índices de mortalidad por enfermedades como la tuberculosis, la septicemia o la infección urinaria, lo que a su vez dio paso al avance científico en otras enfermedades como el cáncer.
Sin embargo, en los últimos años, debido al mal uso de los antibióticos –ingerirlos sin receta médica previa, no cumplir los horarios establecidos o no finalizar el proceso de curación– ha hecho que las bacterias se vuelvan resistentes a los medicamentos.
Según explica el doctor José Luis del Pozo, director del Área de enfermedades infecciosas de la Clínica Universidad de Navarra, “la situación actual es un callejón sin salida. (…) Frente a este problema los laboratorios no pueden dar una respuesta rápida, ya que tardan más de diez años en desarrollar antibióticos nuevos, una inversión que es muy difícil de recuperar porque las compañías médicas no lo perciben como rentable”.
En busca de nuevos fármacos
Desde la Universidad de Illinois, un equipo de químicos liderado por Paul J. Hergenrother ha logrado aislar un compuesto que podría ser eficaz contra las bacterias súper resistentes.
En concreto, el objetivo han sido las bacterias gram negativas, cuyo sistema de defensa no permite penetrar a los antibióticos y hasta ahora solo eran eliminables si se atacaba también a otras células beneficiosas de nuestro organismo.
El equipo tomó los compuestos de anteriores fármacos y los modificó estructuralmente para que atacaran a las gram negativas. De entre los compuestos modificados, uno de ellos, la fabimicina, demostró ser eficaz sin atacar a otras bacterias inofensivas del organismo.

Posteriormente, este compuesto molecular se probó en ratones con neumonía o infecciones urinarias y demostró reducir los niveles de bacterias al estadio previo a la infección e incluso menores.
Según indicaron los investigadores, este éxito abre la posibilidad de integrar este compuesto en un futuro fármaco para las infecciones en humanos.